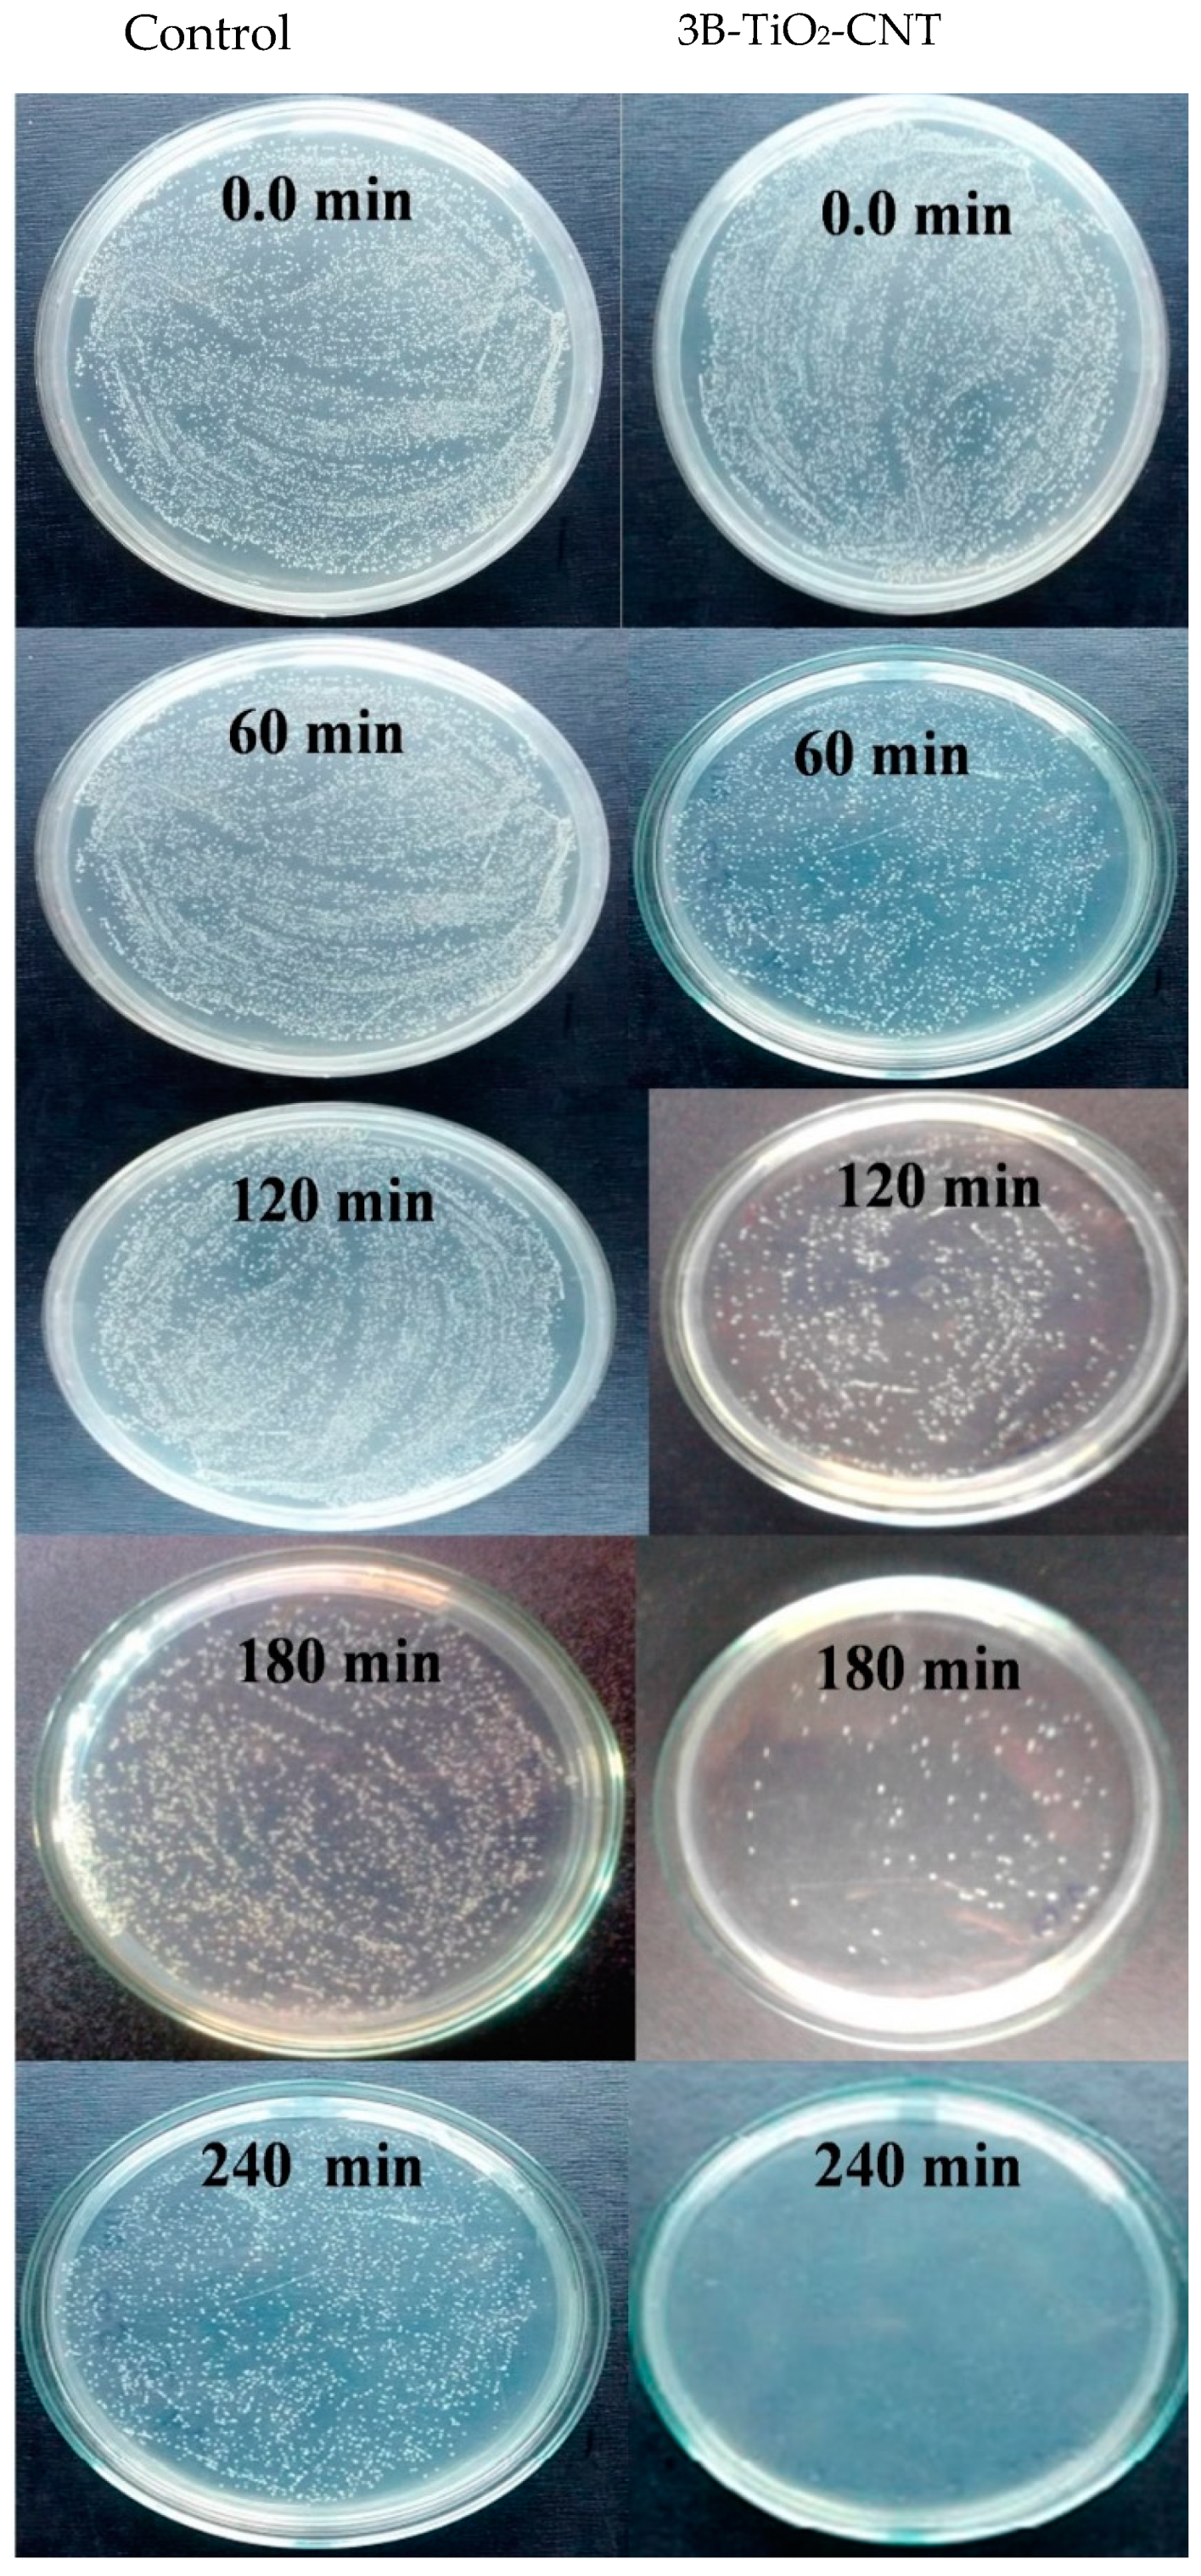
Catalysts 10 00632 g011 Catalysts 10 00632 g011

Boron-Doped TiO2-CNT Nanocomposites with Improved Photocatalytic Efficiency toward Photodegradation of Toluene Gas and Photo-Inactivation of Escherichia coli
Abstract
1. Introduction
2. Results and Discussion
2.1. X-ray Diffraction Studies
2.2. UV-Vis Diffuse Reflectance Spectroscopy
2.3. Photoluminescence Analysis
2.4. Transmission Electron Microscopy Analysis
2.5. X-ray Photoelectron Spectroscopy Studies
2.6. Photodegradation of Toluene Gas
2.7. Photocatalytic Inactivation of Bacteria
3. Materials and Methods
3.1. Materials
3.2. Preparation of Boron-Doped TiO2-CNT Nanocomposites
3.3. Photodegradation of Toluene Gas
3.4. Photo-Inactivation of E. coli
3.5. Characterization
4. Conclusions
Author Contributions
Funding
Conflicts of Interest
References
- Nigar, H.; Julián, I.; Mallada, R.; Santamaría, J. Microwave-assisted catalytic combustion for the efficient continuous cleaning of VOC-containing air streams. Environ. Sci. Technol. 2018, 52, 5892–5901. [Google Scholar] [CrossRef] [PubMed]
- Park, J.-H.; Seo, Y.-S.; Kim, H.-S.; Kim, I.-K. Photodegradation of benzene, toluene, ethylbenzene, and xylene by fluidized bed gaseous reactor with TiO2/SiO2 photocatalysts. Korean J. Chem. Eng. 2011, 28, 1693–1697. [Google Scholar] [CrossRef]
- Sarigiannis, D.A.; Karakitsios, S.P.; Gotti, A.; Liakos, I.L.; Katsoyiannis, A. Exposure to major volatile organic compounds and carbonyls in European indoor environments and associated health risk. Environ. Int. 2011, 37, 743–765. [Google Scholar] [CrossRef]
- Pham, T.-D.; Lee, B.-K. Novel adsorption and photocatalytic oxidation for removal of gaseous toluene by V-doped TiO2/PU under visible light. J. Hazard. Mater. 2015, 300, 493–503. [Google Scholar] [CrossRef] [PubMed]
- Neubert, D.; Gericke, C.; Hanke, B.; Beckmann, G.; Baltes, M.M.; Kühl, K.-P.; Bochert, G.; Hartmann, J. Multicenter field trial on possible health effects of toluene. II. Cross-sectional evaluation of acute low-level exposure. Toxicology 2001, 168, 159–183. [Google Scholar] [CrossRef]
- Liou, T.-H.; Hung, L.-W.; Liu, C.-L.; Zhang, T.-Y. Direct synthesis of nano titania on highly-ordered mesoporous SBA-15 framework for enhancing adsorption and photocatalytic activity. J. Porous Mater. 2018, 25, 1337–1347. [Google Scholar] [CrossRef]
- Yang, C.-C.; Doong, R.-A.; Chen, K.-F.; Chen, G.-S.; Tsai, Y.-P. The photocatalytic degradation of methylene blue by green semiconductor films that is induced by irradiation by a light-emitting diode and visible light. J. Air Waste Manag. Assoc. 2018, 68, 29–38. [Google Scholar] [CrossRef]
- St. Denis, T.G.; Dai, T.; Izikson, L.; Astrakas, C.; Anderson, R.R.; Hamblin, M.R.; Tegos, G.P. All you need is light. Virulence 2011, 2, 509–520. [Google Scholar] [CrossRef]
- Byrne, A.J.; Dunlop, S.P.; Hamilton, W.J.; Fernández-Ibáñez, P.; Polo-López, I.; Sharma, K.P.; Vennard, S.A. A Review of Heterogeneous Photocatalysis for Water and Surface Disinfection. Molecules 2015, 20, 5574–5615. [Google Scholar] [CrossRef]
- McCullagh, C.; Robertson, J.M.C.; Bahnemann, D.W.; Robertson, P.K.J. The application of TiO2 photocatalysis for disinfection of water contaminated with pathogenic micro-organisms: A review. Res. Chem. Int. 2007, 33, 359–375. [Google Scholar] [CrossRef]
- Planas, O.; Bresolí-Obach, R.; Nos, J.; Gallavardin, T.; Ruiz-González, R.; Agut, M.; Nonell, S. Synthesis, photophysical characterization, and photoinduced antibacterial activity of methylene blue-loaded amino- and mannose-targeted mesoporous silica nanoparticles. Molecules 2015, 20, 6284–6298. [Google Scholar] [CrossRef] [PubMed]
- Bartzatt, R.; Cirillo, S.; Cirillo, J. Antibacterial derivatives of ciprofloxacin to inhibit the growth of necrotizing fasciitis associated penicillin-resistant Escherichia coli. J. Pharm. 2013, 2013, 1–7. [Google Scholar]
- Bohara, R.A.; Pawar, S.H. Innovative developments in bacterial detection with magnetic nanoparticles. Appl. Biochem. Biotechnol. 2015, 176, 1044–1058. [Google Scholar] [CrossRef] [PubMed]
- Meshram, J.V.; Koli, V.B.; Phadatare, M.R.; Pawar, S.H. Anti-microbial surfaces: An approach for deposition of ZnO nanoparticles on PVA-Gelatin composite film by screen printing technique. Mater. Sci. Eng. C 2017, 73, 257–266. [Google Scholar] [CrossRef] [PubMed]
- Ziental, D.; Czarczynska-Goslinska, B.; Mlynarczyk, D.T.; Glowacka-Sobotta, A.; Stanisz, B.; Goslinski, T.; Sobotta, L. Titanium dioxide nanoparticles: Prospects and applications in medicine. Nanomaterials 2020, 10, 387. [Google Scholar] [CrossRef] [PubMed]
- Fu, H.; Yang, L.; Hu, D.; Yu, C.; Ling, Y.; Xie, Y.; Li, S.; Zhao, J. Titanium dioxide nano-heterostructure with nanoparticles decorating nanowires for high-performance photocatalysis. Int. J. Hydrogen Energy 2018, 43, 10359–10367. [Google Scholar] [CrossRef]
- Bai, Y.; Mora-Seró, I.; De Angelis, F.; Bisquert, J.; Wang, P. Titanium dioxide nanomaterials for photovoltaic applications. Chem. Rev. 2014, 114, 10095–10130. [Google Scholar] [CrossRef]
- Marković, D.; Milovanovic, S.; Radovanović, Ž.; Zizovic, I.; Saponjic, Z.; Radetić, M. floating photocatalyst based on poly(ε-caprolactone) foam and TiO2 nanoparticles for removal of textile dyes. Fibers Polym. 2018, 19, 1219–1227. [Google Scholar] [CrossRef]
- Wang, Z.; Lang, X. Visible light photocatalysis of dye-sensitized TiO2: The selective aerobic oxidation of amines to imines. Appl. Catal. B Environ. 2018, 224, 404–409. [Google Scholar] [CrossRef]
- Eversfield, P.; Lange, T.; Hunger, M.; Klemm, E. Selective oxidation of o-xylene to phthalic anhydride on tungsten, tin, and potassium promoted VOx on TiO2 monolayer catalysts. Catal. Today 2019, 333, 120–126. [Google Scholar] [CrossRef]
- Ren, Y.; Sun, D.; Cao, Y.; Tsao, H.N.; Yuan, Y.; Zakeeruddin, S.M.; Wang, P.; Grätzel, M. A Stable blue photosensitizer for color palette of dye-sensitized solar cells reaching 12.6% efficiency. J. Am. Chem. Soc. 2018, 140, 2405–2408. [Google Scholar] [CrossRef] [PubMed]
- Lusvardi, G.; Barani, C.; Giubertoni, F.; Paganelli, G. Synthesis and characterization of TiO₂ nanoparticles for the reduction of water pollutants. Materials 2017, 10, 1208. [Google Scholar] [CrossRef] [PubMed]
- Carlucci, C.; Xu, H.; Scremin, B.; Giannini, C.; Sibillano, T.; Carlino, E.; Videtta, V.; Gigli, G.; Ciccarella, G. Controllable one-pot synthesis of anatase TiO2 nanorods with the microwave-solvothermal method. Sci. Adv. Mater. 2014, 6, 1–8. [Google Scholar] [CrossRef]
- Yadav, H.M.; Otari, S.V.; Koli, V.B.; Mali, S.S.; Hong, C.K.; Pawar, S.H.; Delekar, S.D. Preparation and characterization of copper-doped anatase TiO2 nanoparticles with visible light photocatalytic antibacterial activity. J. Photochem. Photobiol. A Chem. 2014, 280, 32–38. [Google Scholar] [CrossRef]
- Barkul, R.P.; Koli, V.B.; Shewale, V.B.; Patil, M.K.; Delekar, S.D. Visible active nanocrystalline N-doped anatase TiO2 particles for photocatalytic mineralization studies. Mater. Chem. Phys. 2016, 173, 42–51. [Google Scholar] [CrossRef]
- Koli, V.B.; Delekar, S.D.; Pawar, S.H. Photoinactivation of bacteria by using Fe-doped TiO2-MWCNTs nanocomposites. J. Mater. Sci. Mater. Med. 2016, 27, 177. [Google Scholar] [CrossRef] [PubMed]
- Deshmukh, S.P.; Mullani, S.B.; Koli, V.B.; Patil, S.M.; Kasabe, P.J.; Dandge, P.B.; Pawar, S.A.; Delekar, S.D. Ag Nanoparticles Connected to the Surface of TiO2 Electrostatically for Antibacterial Photoinactivation Studies. Photochem. Photobiol. 2018, 94, 1249–1262. [Google Scholar] [CrossRef]
- Al Qarni, F.; Alomair, N.A.; Mohamed, H.H. Environment-friendly nanoporous titanium dioxide with enhanced photocatalytic activity. Catalysts 2019, 9, 799. [Google Scholar] [CrossRef]
- Olowoyo, J.O.; Kumar, M.; Jain, S.L.; Babalola, J.O.; Vorontsov, A.V.; Kumar, U. Insights into Reinforced Photocatalytic Activity of the CNT–TiO2 Nanocomposite for CO2 Reduction and Water Splitting. J. Phys. Chem. C 2019, 123, 367–378. [Google Scholar] [CrossRef]
- Gopannagari, M.; Kumar, D.P.; Park, H.; Kim, E.H.; Bhavani, P.; Reddy, D.A.; Kim, T.K. Influence of surface-functionalized multi-walled carbon nanotubes on CdS nanohybrids for effective photocatalytic hydrogen production. Appl. Catal. B Environ. 2018, 236, 294–303. [Google Scholar] [CrossRef]
- Blanchard, N.P.; Hatton, R.A.; Silva, S.R.P. Tuning the work function of surface oxidized multi-wall carbon nanotubes via cation exchange. Chem. Phys. Lett. 2007, 434, 92–95. [Google Scholar] [CrossRef]
- Wang, L.; Yao, Z.; Jia, F.; Chen, B.; Jiang, Z. A facile synthesis of ZnxCd1-xS/CNTs nanocomposite photocatalyst for H2 production. Dalton Trans. 2013, 42, 9976–9981. [Google Scholar] [CrossRef] [PubMed]
- Vijayan, B.K.; Dimitrijevic, N.M.; Finkelstein-Shapiro, D.; Wu, J.; Gray, K.A. Coupling titania nanotubes and carbon nanotubes to create photocatalytic nanocomposites. ACS Catal. 2012, 2, 223–229. [Google Scholar] [CrossRef]
- Quesada-González, M.; Boscher, N.D.; Carmalt, C.J.; Parkin, I.P. Interstitial boron-doped TiO2 thin films: The significant effect of boron on TiO2 coatings grown by atmospheric pressure chemical vapor deposition. ACS Appl. Mater. Interfaces 2016, 8, 25024–25029. [Google Scholar] [CrossRef] [PubMed]
- Carlucci, C.; Scremin, B.F.; Sibillano, T.; Giannini, C.; Filippo, E.; Perulli, P.; Capodilupo, A.L.; Corrente, G.A.; Ciccarella, G. Microwave-assisted synthesis of boron-modified TiO2 nanocrystals. Inorganics 2014, 2, 264–277. [Google Scholar] [CrossRef]
- Hong, X.; Kang, Y.; Zhen, C.; Kang, X.D.; Yin, L.; Irvine, J.; Wang, L.; Liu, G.; Cheng, H.-M. Maximizing the visible light photoelectrochemical activity of B/N-doped anatase TiO2 microspheres with exposed dominant {001} facets. Sci. China Mater. 2018, 61, 831–838. [Google Scholar] [CrossRef]
- Sopchenski, L.; Cogo, S.; Dias-Ntipanyj, M.F.; Elifio-Espósito, S.; Popat, K.C.; Soares, P. Bioactive and antibacterial boron-doped TiO2 coating obtained by PEO. Appl. Surf. Sci. 2018, 458, 49–58. [Google Scholar] [CrossRef]
- Sohail, M.; Xue, H.; Jiao, Q.; Li, H.; Khan, K.; Wang, S.; Feng, C.; Zhao, Y. Synthesis of well-dispersed TiO2/CNTs@CoFe2O4 nanocomposites and their photocatalytic properties. Mater. Res. Bull. 2018, 101, 83–89. [Google Scholar] [CrossRef]
- Tan, T.L.; Lai, C.W.; Hong, S.L.; Rashid, S.A. New insights into the photocatalytic endocrine disruptors dimethyl phathalate esters degradation by UV/MWCNTs-TiO2 nanocomposites. J. Photochem. Photobiol. A Chem. 2018, 364, 177–189. [Google Scholar] [CrossRef]
- Akalework, N.; Pan, C.-J.; Su, W.-N.; Rick, J.; Tsai, M.-C.; Lee, J.-F.; Lin, J.-M.; Tsai, L.Y.; Hwang, B.J. Ultrathin TiO2-coated MWCNTs with excellent conductivity and SMSI nature as Pt catalyst support for oxygen reduction reaction in PEMFCs. J. Mater. Chem. 2012, 22, 20977–20985. [Google Scholar] [CrossRef]
- Koli, V.B.; Dhodamani, A.G.; Delekar, S.D.; Pawar, S.H. In situ sol-gel synthesis of anatase TiO2-MWCNTs nanocomposites and their photocatalytic applications. J. Photochem. Photobiol. A Chem. 2017, 333, 40–48. [Google Scholar] [CrossRef]
- Li, L.; Yang, Y.; Liu, X.; Fan, R.; Shi, Y.; Li, S.; Zhang, L.; Fan, X.; Tang, P.; Xu, R.; et al. A direct synthesis of B-doped TiO2 and its photocatalytic performance on the degradation of RhB. Appl. Surf. Sci. 2013, 265, 36–40. [Google Scholar] [CrossRef]
- Simsek, E.B. Solvothermal synthesized boron doped TiO2 catalysts: Photocatalytic degradation of endocrine disrupting compounds and pharmaceuticals under visible light irradiation. Appl. Catal. B Environ. 2017, 200, 309–322. [Google Scholar] [CrossRef]
- Szkoda, M.; Siuzdak, K.; Lisowska-Oleksiak, A. Non-metal doped TiO2 nanotube arrays for high efficiency photocatalytic decomposition of organic species in water. Phys. E Low-Dimens. Syst. Nanostruct. 2016, 84, 141–145. [Google Scholar] [CrossRef]
- Zhou, M.; Zhang, J.; Cheng, B.; Yu, H. Enhancement of visible-light photocatalytic activity of mesoporous Au-TiO2 nanocomposites by surface plasmon resonance. Int. J. Photoenergy 2012, 2012, 1–10. [Google Scholar]
- Asahi, R.; Morikawa, T.; Ohwaki, T.; Aoki, K.; Taga, Y. Visible-light photocatalysis in nitrogen-doped titanium oxides. Science 2001, 293, 269–271. [Google Scholar] [CrossRef]
- Koli, V.; Dhodamani, A.; More, K.; Acquah, S.F.; Panda, D.K.; Pawar, S.; Delekar, S. A simple strategy for the anchoring of anatase titania on multi-walled carbon nanotubes for solar energy harvesting. Sol. Energy 2017, 149, 188–194. [Google Scholar] [CrossRef]
- Koli, V.B.; Dhodamani, A.G.; Raut, A.V.; Thorat, N.D.; Pawar, S.H.; Delekar, S.D. Visible light photo-induced antibacterial activity of TiO2-MWCNTs nanocomposites with varying the contents of MWCNTs. J. Photochem. Photobiol. A Chem. 2016, 328, 50–58. [Google Scholar] [CrossRef]
- Koli, V.B.; Mavengere, S.; Kim, J.-S. Boron-doped TiO2–CNTs nanocomposites for photocatalytic application. J. Mater. Sci. Mater. Electron. 2018, 29, 16660–16672. [Google Scholar] [CrossRef]
- Khan, R.; Kim, S.W.; Kim, T.-J.; Nam, C.-M. Comparative study of the photocatalytic performance of boron–iron Co-doped and boron-doped TiO2 nanoparticles. Mater. Chem. Phys. 2008, 112, 167–172. [Google Scholar] [CrossRef]
- Reddy, N.R.; Kumari, M.M.; Cheralathan, K.K.; Shankar, M.V. Enhanced photocatalytic hydrogen production activity of noble metal-free MWCNT-TiO2 nanocomposites. Int. J. Hydrogen Energy 2018, 43, 4036–4043. [Google Scholar] [CrossRef]
- Alwash, A.; Adil, H.; Hussain, Z.; Yousif, E. Potential of carbon nanotubes in enhance of photocatalyst activity. Arch. Nano Op. Acc. J. 2018, 1, 65–70. [Google Scholar]
- Schütt, F.; Signetti, S.; Krüger, H.; Röder, S.; Smazna, D.; Kaps, S.; Gorb, S.N.; Mishra, Y.K.; Pugno, N.M.; Adelung, R. Hierarchical self-entangled carbon nanotube tube networks. Nat. Commun. 2017, 8, 1–10. [Google Scholar] [CrossRef] [PubMed]
- Jeong, J.-H.; Jung, D.-w.; Shin, E.W.; Oh, E.-S. Boron-doped TiO2 anode materials for high-rate lithium ion batteries. J. Alloy. Compd. 2014, 604, 226–232. [Google Scholar] [CrossRef]
- Subramanian, A.; Wang, H.-W. Effects of boron doping in TiO2 nanotubes and the performance of dye-sensitized solar cells. Appl. Surf. Sci. 2012, 258, 6479–6484. [Google Scholar] [CrossRef]
- Zhang, W.; Yang, B.; Chen, J. Effects of calcination temperature on the preparation of boron-doped TiO2 by sol-gel method. Int. J. Photoenergy 2012, 2012, 1–8. [Google Scholar]
- Vilian, A.E.; Veeramani, V.; Chen, S.-M.; Madhu, R.; Kwak, C.H.; Huh, Y.S.; Han, Y.-K. Immobilization of myoglobin on Au nanoparticle-decorated carbon nanotube/polytyramine composite as a mediator-free H2O2 and nitrite biosensor. Sci. Rep. 2015, 5, 1–10. [Google Scholar] [CrossRef] [PubMed]
- Yan, X.-b.; Tay, B.K.; Yang, Y. Dispersing and functionalizing multiwalled carbon nanotubes in TiO2 sol. J. Phys. Chem. B 2006, 110, 25844–25849. [Google Scholar] [CrossRef]
- Matos, J.; Laine, J.; Herrmann, J.-M.; Uzcategui, D.; Brito, J. Influence of activated carbon upon titania on aqueous photocatalytic consecutive runs of phenol photodegradation. Appl. Catal. B Environ. 2007, 70, 461–469. [Google Scholar] [CrossRef]
- Zhang, C.; Liu, Y.; Zhou, J.; Jin, W.; Chen, W. Tunability of photo-catalytic selectivity of B-doped anatase TiO2 microspheres in the visible light. Dyes Pigment. 2018, 156, 213–218. [Google Scholar] [CrossRef]
- Pan, H.; Zhang, Y.-W.; Shenoy, V.B.; Gao, H. Ab initio study on a novel photocatalyst: Functionalized graphitic carbon nitride nanotube. Acs Catal. 2011, 1, 99–104. [Google Scholar] [CrossRef]
- Fu, Y.; Chang, C.; Chen, P.; Chu, X.; Zhu, L. Enhanced photocatalytic performance of boron doped Bi2WO6 nanosheets under simulated solar light irradiation. J. Hazard. Mater. 2013, 254, 185–192. [Google Scholar] [CrossRef]
- Ghartavol, H.M.; Mohammadi, M.R.; Afshar, A.; Li, Y. On the assessment of incorporation of CNT–TiO2 core–shell structures into nanoparticle TiO2 photoanodes in dye-sensitized solar cells. Photochem. Photobiol. Sci. 2019, 18, 1840–1850. [Google Scholar] [CrossRef] [PubMed]
- Koli, V.B.; Mavengere, S.; Kim, J.-S. Photocatalytic properties of TiO2-SiO2-coated concrete on toluene gas. Mater. Res. Express 2018, 5, 125006. [Google Scholar] [CrossRef]
- Akhavan, O.; Abdolahad, M.; Abdi, Y.; Mohajerzadeh, S. Synthesis of titania/carbon nanotube heterojunction arrays for photoinactivation of E. coli in visible light irradiation. Carbon 2009, 47, 3280–3287. [Google Scholar] [CrossRef]
- Sunada, K.; Watanabe, T.; Hashimoto, K. Studies on photokilling of bacteria on TiO2 thin film. J. Photochem. Photobiol. A Chem. 2003, 156, 227–233. [Google Scholar] [CrossRef]
- Yadav, H.M.; Kim, J.-S. Solvothermal synthesis of anatase TiO2-graphene oxide nanocomposites and their photocatalytic performance. J. Alloy. Compd. 2016, 688, 123–129. [Google Scholar] [CrossRef]
- Koli, V.B.; Kim, J.-S. Photocatalytic oxidation for removal of gases toluene by TiO2-CeO2 nanocomposites under UV light irradiation. Mater. Sci. Semicond. Process. 2019, 94, 70–79. [Google Scholar] [CrossRef]
- Yadav, H.M.; Kolekar, T.V.; Pawar, S.H.; Kim, J.-S. Enhanced photocatalytic inactivation of bacteria on Fe-containing TiO2 nanoparticles under fluorescent light. J. Mater. Sci. Mater. Med. 2016, 27, 57. [Google Scholar] [CrossRef]

| Samples | Crystallite Size (D) in nm | Optical Band Gap (Eg) eV |
|---|---|---|
| TiO2 | 10 | 3.2 |
| 3B-TiO2 | 17 | 2.7 |
| 1B-TiO2-CNT | 12 | 3.0 |
| 2B-TiO2-CNT | 14 | 2.8 |
| 3B-TiO2-CNT | 17 | 2.6 |
| 4B-TiO2-CNT | 18 | 2.6 |
© 2020 by the authors. Licensee MDPI, Basel, Switzerland. This article is an open access article distributed under the terms and conditions of the Creative Commons Attribution (CC BY) license (http://creativecommons.org/licenses/by/4.0/).
Share and Cite
Koli, V.B.; Ke, S.-C.; Dodamani, A.G.; Deshmukh, S.P.; Kim, J.-S. Boron-Doped TiO2-CNT Nanocomposites with Improved Photocatalytic Efficiency toward Photodegradation of Toluene Gas and Photo-Inactivation of Escherichia coli. Catalysts 2020, 10, 632. https://doi.org/10.3390/catal10060632
Koli VB, Ke S-C, Dodamani AG, Deshmukh SP, Kim J-S. Boron-Doped TiO2-CNT Nanocomposites with Improved Photocatalytic Efficiency toward Photodegradation of Toluene Gas and Photo-Inactivation of Escherichia coli. Catalysts. 2020; 10(6):632. https://doi.org/10.3390/catal10060632
Chicago/Turabian StyleKoli, Valmiki B., Shyue-Chu Ke, Ananta G. Dodamani, Shamkumar P. Deshmukh, and Jung-Sik Kim. 2020. "Boron-Doped TiO2-CNT Nanocomposites with Improved Photocatalytic Efficiency toward Photodegradation of Toluene Gas and Photo-Inactivation of Escherichia coli" Catalysts 10, no. 6: 632. https://doi.org/10.3390/catal10060632
APA StyleKoli, V. B., Ke, S.-C., Dodamani, A. G., Deshmukh, S. P., & Kim, J.-S. (2020). Boron-Doped TiO2-CNT Nanocomposites with Improved Photocatalytic Efficiency toward Photodegradation of Toluene Gas and Photo-Inactivation of Escherichia coli. Catalysts, 10(6), 632. https://doi.org/10.3390/catal10060632





